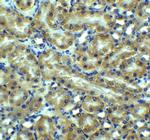
TRAIL-R2 (DR5) Antibody in Immunohistochemistry (Paraffin) (IHC (P))

Search
Invitrogen
TRAIL-R2 (DR5) Polyclonal Antibody
{{$productOrderCtrl.translations['antibody.pdp.commerceCard.promotion.promotions']}}
{{$productOrderCtrl.translations['antibody.pdp.commerceCard.promotion.viewpromo']}}
{{$productOrderCtrl.translations['antibody.pdp.commerceCard.promotion.promocode']}}: {{promo.promoCode}} {{promo.promoTitle}} {{promo.promoDescription}}. {{$productOrderCtrl.translations['antibody.pdp.commerceCard.promotion.learnmore']}}
FIGURE: 1 / 11
TRAIL-R2 (DR5) Antibody (PA5-19895) in ICC/IF

Please note: We are reviewing Western blot images included in the antibody testing data in our catalog, including those provided by third parties. Unless expressly labeled or annotated as “raw-unedited”, Western blot images included in the antibody testing data in our catalog may have been edited, optimized or otherwise adjusted for presentation.
Product Details
PA5-19895
Species Reactivity
Published species
Host/Isotype
Class
Type
Immunogen
Conjugate
Form
Concentration
Amount
Purification
Storage buffer
Contains
Storage conditions
Shipping conditions
RRID
Product Specific Information
A suggested positive control is Hela cell lysate.
PA5-19895 can be used with blocking peptide PEP-0021.
The PA5-19895 immunogen is located within the last 50 amino acids of DR5.
Predicted molecular ~ 48kD and 45kD. In Western blot applications, this antibody has been observed to detect a band at: 48kD and 45kD
Target Information
DR5 (Apo2, TRAIL-R2, TRICK2, KILLER) is a recently identified death domain containing receptor for TRAIL, which mediates TRAIL induced apoptosis. DR5 is a member of the TNF-receptor superfamily, and contains an intracellular death domain. DR5 can be activated by tumor necrosis factor-related apoptosis inducing ligand (TNFSF10/TRAIL/APO-2L), and transduces an apoptosis signal. Studies with FADD-deficient mice suggested that FADD, a death domain containing adaptor protein, is required for the apoptosis mediated by DR5. Two transcript variants encoding different isoforms of DR5 and one non-coding transcript have been found. Overexpression of DR5 induces apoptosis and activates NF-kappa-B. DR5 is expressed in a number of cell types, and to particularly high levels in lymphocytes and spleen. Diseases associated with DR5 dysfunction include squamous cell carcinoma, and diffuse infiltrative lymphocytosis syndrome.
For Research Use Only. Not for use in diagnostic procedures. Not for resale without express authorization.
Bioinformatics
Protein Aliases: CD262; Death receptor 5; dr-5; KILLER/DR5 TRAIL death-inducing receptor; MK; sCD262; soluble CD262; Tumor necrosis factor receptor superfamily member 10B; tumor necrosis factor receptor superfamily, member 10b
Gene Aliases: DR5; KILLER; Ly98; MK; Tnfrsf10b; TRAILR2; TRICK2A; TRICK2B; TRICKB
UniProt ID: (Mouse) Q9QZM4
Entrez Gene ID: (Mouse) 21933, (Rat) 364420

Performance Guarantee
If an Invitrogen™ antibody doesn't perform as described on our website or datasheet,we'll replace the product at no cost to you, or provide you with a credit for a future purchase.*
Learn more
We're here to help
Get expert recommendations for common problems or connect directly with an on staff expert for technical assistance related to applications, equipment and general product use.
Contact tech support

